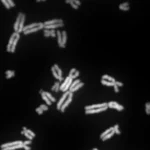

Ученые разработали новый компьютерный язык для моделирования признаков организмов
Один из самых красивых аспектов природы — бесконечное разнообразие форм, цветовых сочетаний и поведения организмов. Эти черты помогают организмам выживать и находить себе пару, например, разноцветный хвост павлина привлекает самок или крылья позволят ему улететь от опасности. Понимание признаков крайне важно для биологов, которые изучают их, чтобы узнать, как организмы эволюционируют и приспосабливаются к различным условиям окружающей среды.
Для этого ученым сначала нужно описать эти черты словами, например, сказать, что хвост павлина «яркий, переливающийся и нарядный». Такой подход подходит для небольших исследований, но когда речь идет о сотнях или даже миллионах различных животных или растений, человеческий мозг не в состоянии уследить за всем.
На помощь могут прийти компьютерные технологии, но даже новейшие технологии искусственного интеллекта не в состоянии понять человеческий язык в той степени, которая необходима биологам. Это существенно затрудняет исследования, поскольку, хотя ученые могут обрабатывать большие объемы данных ДНК, связать эту информацию с физическими признаками все еще очень сложно.
Чтобы решить эту проблему, исследователи из Финского музея естественной истории Джулио Монтанаро и Сергей Тарасов вместе с соавторами создали специальный язык под названием Phenoscript. Этот язык предназначен для описания признаков таким образом, чтобы его могли понять и люди, и компьютеры. Описывать черты с помощью Phenoscript — все равно что программировать компьютерный код для того, как выглядит организм.
В Phenoscript используется так называемая семантическая технология, которая помогает компьютерам понимать смысл слов, подобно тому, как современные поисковые системы понимают разницу между фруктом «яблоко» и технологической компанией «Apple», основываясь на контексте вашего поиска.
«Этот язык все еще тестируется, но он подает большие надежды. По мере того как все больше ученых начнут использовать Phenoscript, он произведет революцию в биологии, сделав огромные объемы данных о признаках доступными для крупномасштабных исследований, что будет способствовать развитию зарождающейся области феномики«, — объясняет Монтанаро.
В своей научной статье, недавно опубликованной в журнале Biodiversity Data Journal, исследователи впервые используют новый язык, создавая семантические фенотипы для четырех видов навозных жуков из рода Grebennikovius. Затем, чтобы продемонстрировать возможности семантического подхода, они применяют простые семантические запросы к созданным фенотипическим описаниям.
Наконец, команда заглядывает еще дальше в будущее, чтобы модернизировать способы работы ученых с информацией о видах. Их следующая цель — интегрировать семантические описания видов с концепцией нанопубликаций, «которая заключает отдельные фрагменты информации во всесторонний граф знаний«.
В результате данные, ставшие частью этого графа, можно будет запрашивать напрямую, обеспечивая тем самым их доступность для поиска, взаимодействия и повторного использования (FAIR) через различные семантические ресурсы.